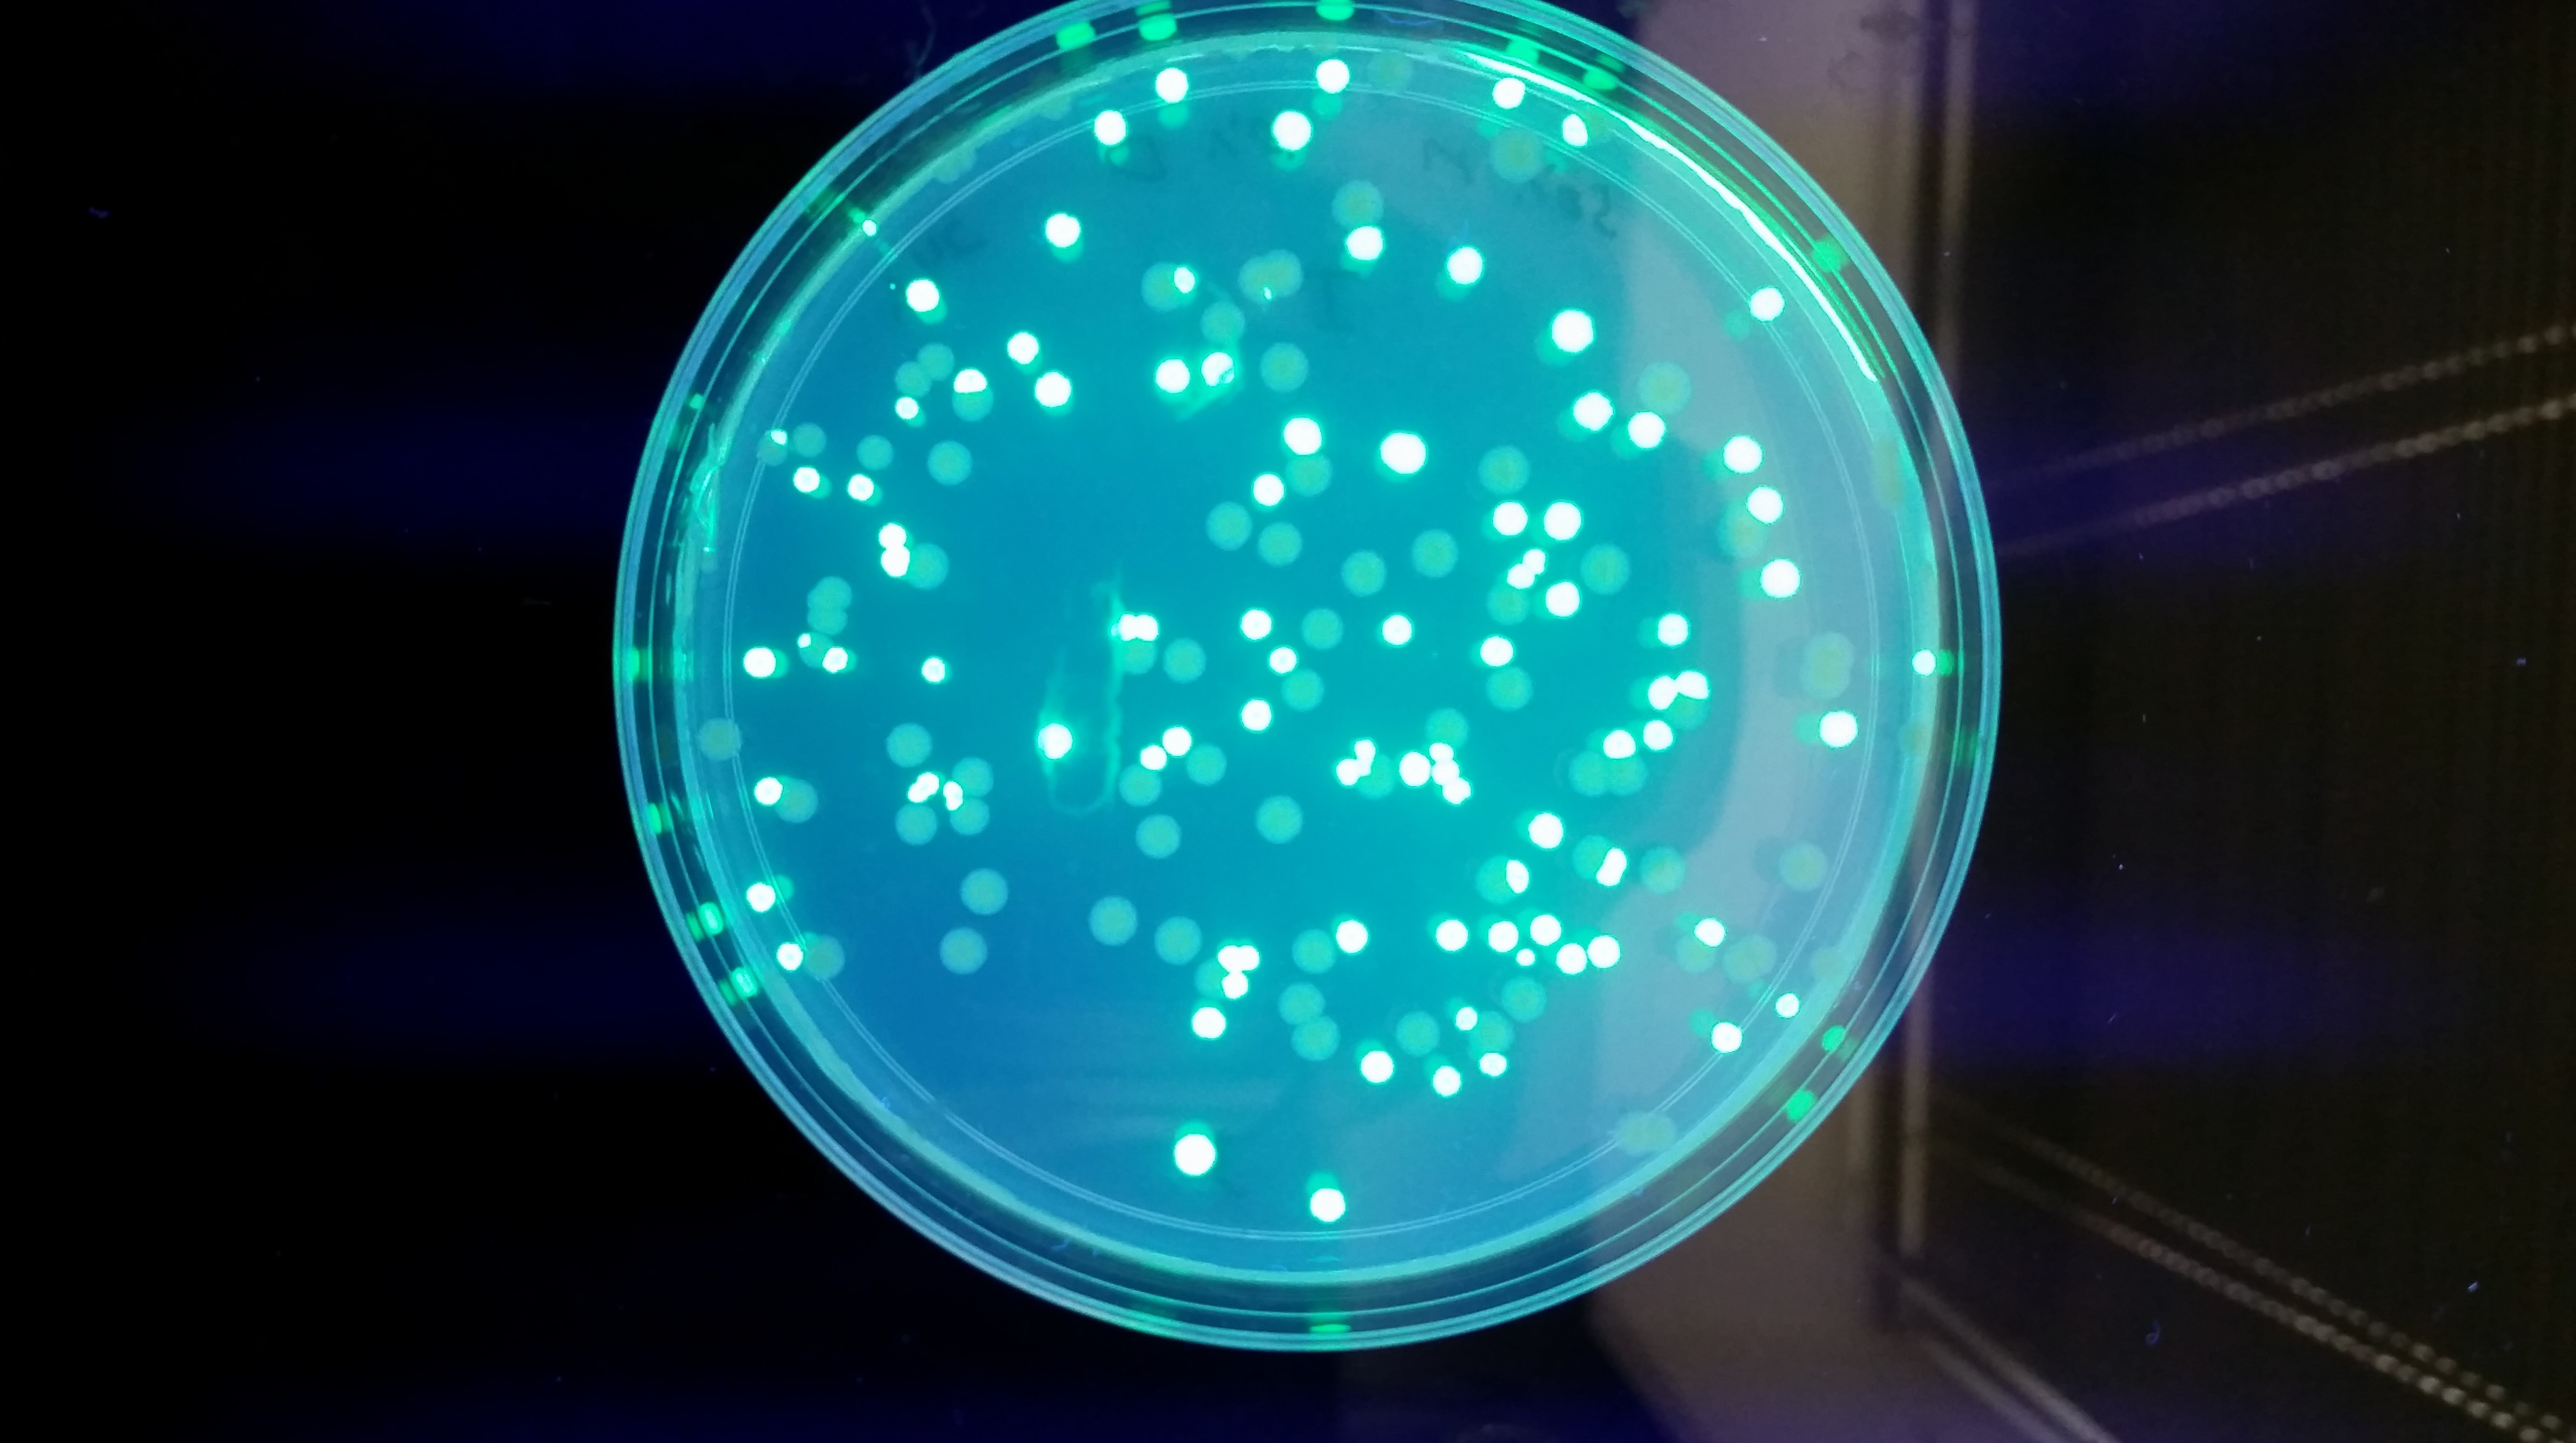

With the widespread use of antimicrobials, the use of alternative strategies to mitigate resistance are needed more than ever before. We are addressing this need by curing bacterial cells of plasmids that commonly resistance genes (R-plasmids). Plasmids are small, self-replicating extra-chromosomal genetic elements that are capable of being transferred from one bacterium to another.
By eliminating (or curing) plasmids from pathogenic bacteria, it may be possible to reduce the spread of antimicrobial resistance genes as well as some virulence factors. The Walk lab is currently screening a number of compounds for their capacity to cure plasmids from disease-causing bacteria. In addition, we are developing new assays to screen for plasmid-curing that are capable of higher throughput and more precise quantitation compared to traditional methodology.